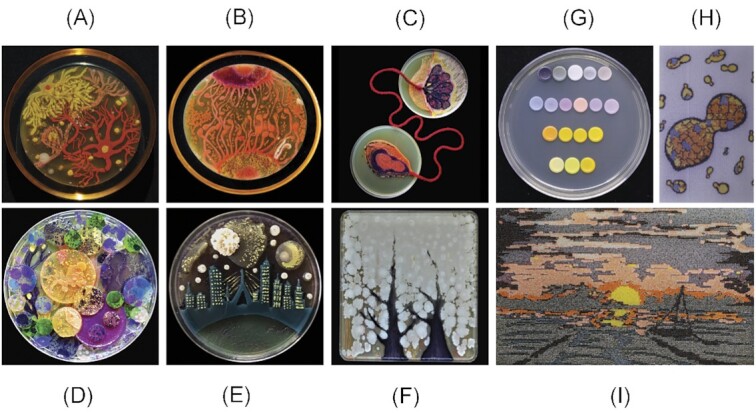
cover image

<Giuliana Ramirez> — HTGAA Spring 2026
About me
I’m Giuliana, a biologist from Ecuador. Since reading a book about Mendelian inheritance as a teenager, I became aware of the existence of genes as regulators of fenotypes. Later on, I became engrossed with red biotechnology, specially potential therapeutical applications of gene editing on human diseases. During my undergraduate studies, I had the opportunity to perform biomed research in a multi-omic oriented lab. This experience taught me that gene regulation is complex: it depends on different omic levels, and is influenced by the cell’s microenvirontment. For me, reconciling this knowledge with circuit designing has become a very engaging approach. I loved the introductory class, as I believe science moves forward when it crosses paths with other ways of thinking—and that Latin America has a lot to contribute to this conversation. If building purpose-driven biotech with local roots resonates with you—let’s chat c:
Contact info
Homework
- Week 1 HW: Principles and Practices
- Week 2 — DNA Read, Write, & Edit
- Week 3— Lab Automation
- Week 4— Protein Design Part 1